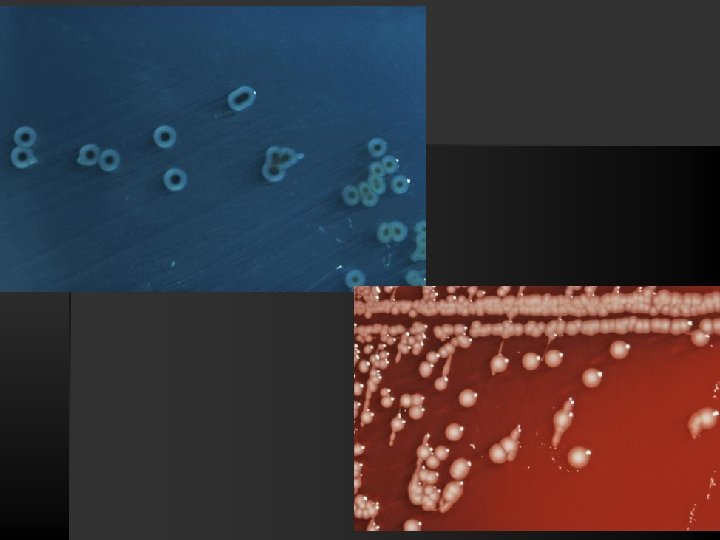
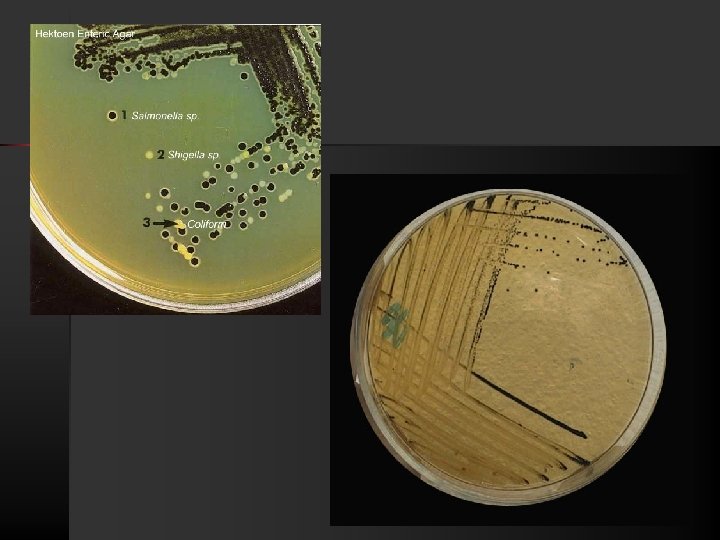
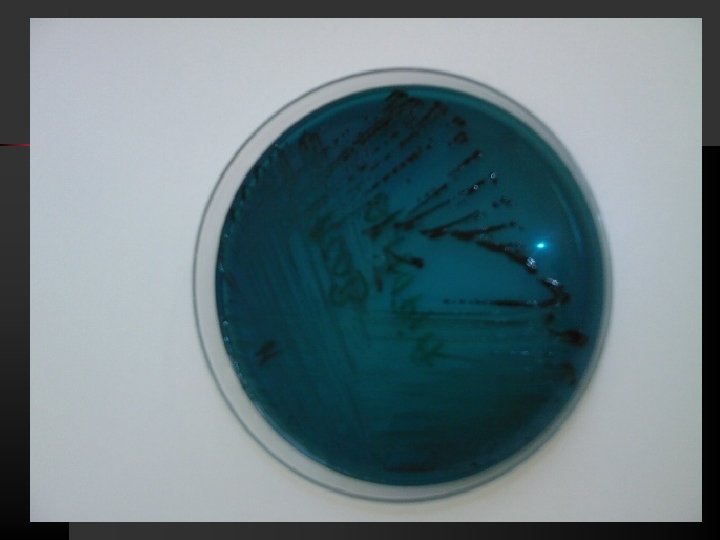
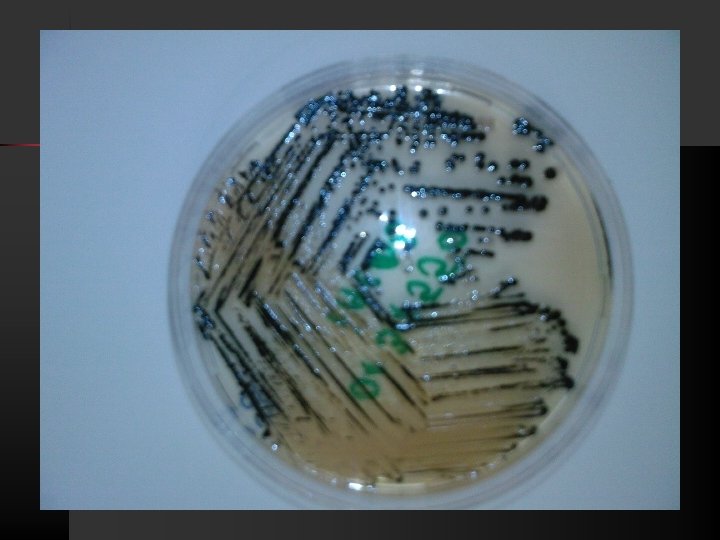
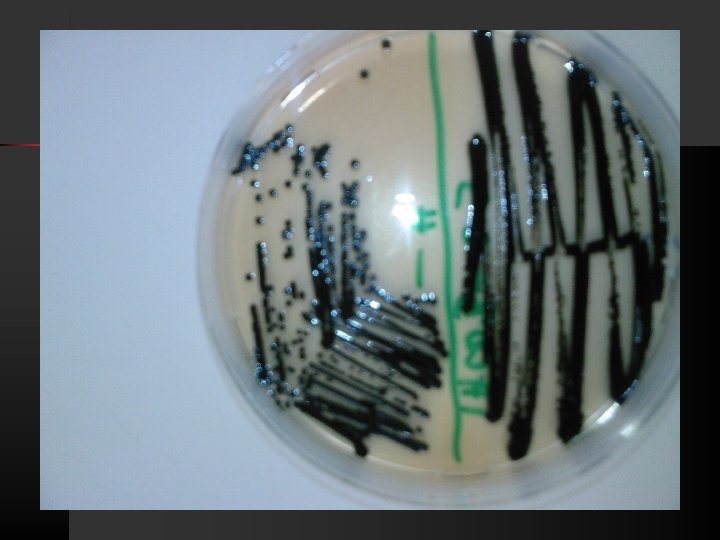
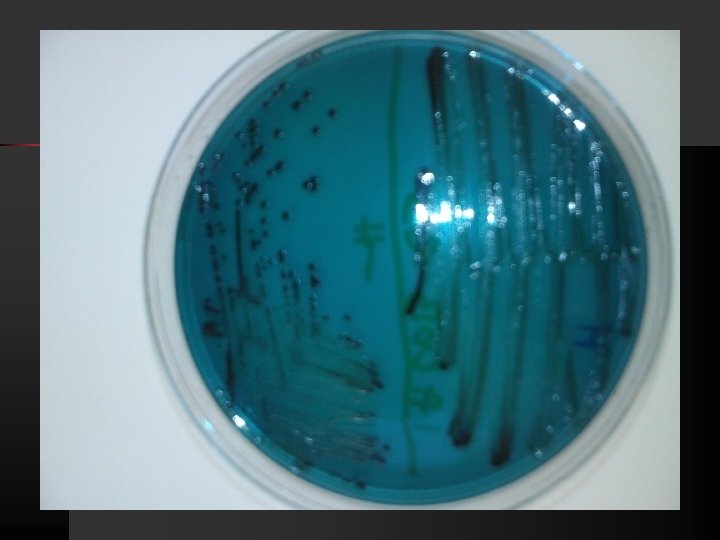
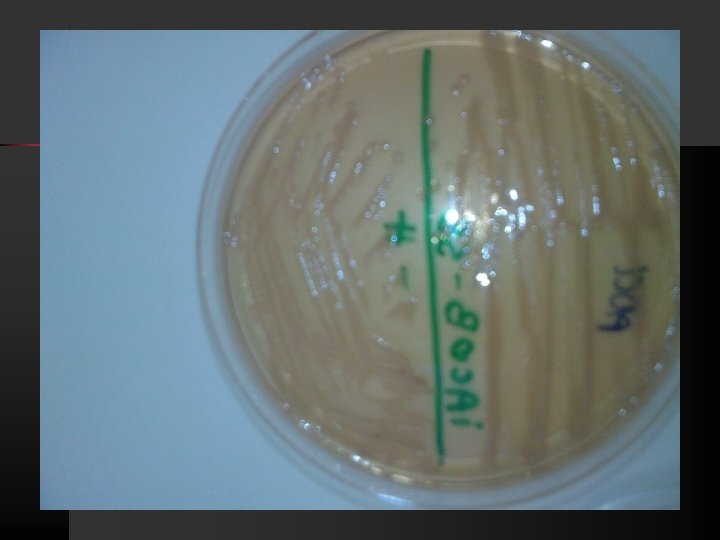

SALMONELLA n Salmonella is a Gramnegative facultative rodshaped

- Slides: 20
SALMONELLA
n Salmonella is a Gram-negative facultative rodshaped bacterium belonging to family Enterobacteriaceae, n Salmonellae live in the intestinal tracts of warm and n In humans, Salmonella are the cause of two diseases called salmonellosis: cold blooded animals. Some species are ubiquitous. Other species are specifically adapted to a particular host. – enteric fever (typhoid), resulting from bacterial invasion of the bloodstream, and – acute gastroenteritis, resulting from a foodborne infection/intoxication.
Morphology Gram – negative rods n uncapsulated (except S. typhi) n unsporulatedsporulaţi n Peritrichous flagella (ensure motility) n
Cultural properties n n Aerobe-anaerobe facultative Grow easily on simple culture media Onto selective and differential media that contain biliary salts and lactose grow like lactose-negative “S” colonies. produce de H 2 S, colonies have a “cateye” appearance.
Biochemical properties n n n n Motile, Lactose negative; acid and gas from glucose, mannitol, maltose, and sorbitol; no Acid from adonitol, sucrose, salicin, lactose ONPG test negative (lactose negative) Indole test negative Methyl red test positive Voges-Proskauer test negative Citrate positive (growth on Simmon's citrate agar) Lysine decarboxylase positive Urease negative Ornithine decarboxylase positive 2 S produced from thiosulfate Phenylalanine and tryptophan deaminase negative Gelatin hydrolysis negative
TSI (Triple Sugar Iron) MIU (Motility Indole Urea). Simmons Citrate medium
Diagnosis n n n The diagnosis of salmonellosis requires bacteriologic isolation of the organisms from appropriate clinical specimens. Laboratory identification of the genus Salmonella is done by biochemical tests; the serologic type is confirmed by serologic testing. Feces, blood, or other specimens should be plated on several nonselective and selective agar media (blood, Mac. Conkey, eosin-methylene blue, bismuth sulfite, Salmonella-Shigella, Hektoen agars) as well as intoenrichment broth such as selenite or tetrathionate.
n n The biochemical reactions of suspicious colonies are then determined on triple sugar iron agar and lysine-iron agar, and a presumptive identification is made. Biochemical identification of salmonellae has been simplified by systems that permit the rapid testing of 10 -20 different biochemical parameters simultaneously. The presumptive biochemical identification of Salmonella then can be confirmed by antigenic analysis of O and H antigens using polyvalent and specific antisera. Salmonella isolates then should be sent to a central or reference laboratory for more comprehensive serologic testing and confirmation.